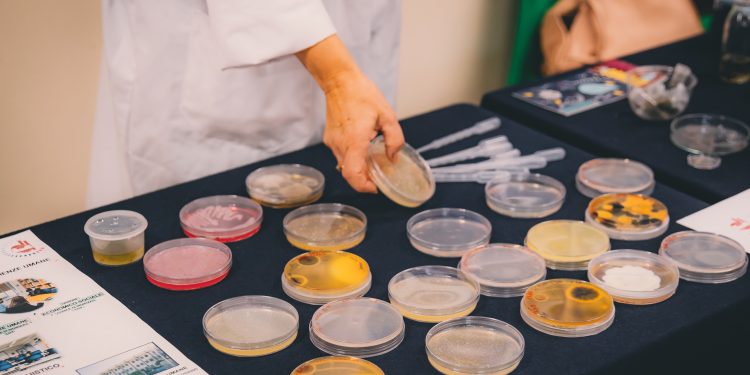
Il sapere in movimento, in arrivo la nuova edizione del Festival Scienza. Tra gli ospiti Luca Bindi, Cristina Messa, Roberto Battiston e Michela Matteoli

Sarà un’edizione di novità per il FestivalScienza, l’appuntamento dedicato alla divulgazione scientifica organizzato a Cagliari (e non solo) da cinque anni dall’associazione ScienzaSocietàScienza: conferenze in lingua sarda, una riflessione sul ruolo delle donne nelle discipline scientifiche, un approfondimento sul grande progetto dell’Einsten Telescope. Per il resto l’evento, oggi alla sua quinta edizione, accoglierà il pubblico con la collaudata e apprezzatissima formula di divulgazione affidata a chi con la scienza lavora ogni giorno.
Il ricco e variegato programma di FestivalScienza, quest’anno dedicato al tema “Scienza in movimento” sarà a Cagliari tra giovedì 9 e martedì 14 novembre, a Nuoro dal 13 al 15, a Oristano il 15 e 16, a Siniscola tra 16 e 18, a Senorbì e Isili tra 20 e 22 novembre, a Iglesias tra 30 novembre e 2 dicembre. Focus sulle scuole, con studenti e studentesse “Che saranno fruitori e attori del festival – come ha sottolineato oggi in conferenza stampa Davide Peddis, professore di chimica all’Università di Genova e neo presidente dell’associazione ScienzaSocietàScienza – con i laboratori interattivi attorno ai quali ruota tutto il programma del festival. Il tema scelto quest’anno – prosegue Peddis – riporta in primo piano il concetto di dinamismo come motore di sviluppo della conoscenza. L’anima della ricerca scientifica, sia nelle scienze umane sia nelle cosiddette scienze dure, risiede proprio in una incessante e intensa dinamica di sviluppo delle idee”. Spazio in calendario a tutte le discipline della scienza: fisica, chimica, medicina, biologia, ambiente, archeologia, matematica, tecnologia, con alcuni appuntamenti dedicati a temi di strettissima attualità come intelligenza artificiale e cambiamenti climatici. In tutto si contano 20 laboratori, 13 conferenze, 16 presentazioni di libri e ancora percorsi naturalistici e museali, giochi, animazioni visite guidate e mostre per tutte le età. Sono oltre 2300 gli studenti e studentesse già prenotati, provenienti da 56 scuole e 22 differenti comuni.

Le conferenze
Il programma prenderà il via giovedì 9 novembre alle 16 a Cagliari, nell’aula magna del Rettorato in via Università a Cagliari, con l’inaugurazione di FestivalScienza: grande attesa per la conferenza di Luca Bindi, direttore del Dipartimento di Scienze della Terra a Firenze e accademico dei Lincei, attorno al tema dei misteriosi quasicristalli; e di Cristina Messa, professoressa di diagnostica per immagini all’Università Bicocca di Milano ed ex ministra dell’Università e della Ricerca per il Governo Draghi.
Da venerdì 10 a martedì 14 novembre l’Exmà di via San Lucifero accoglierà le attività principali del festival, con laboratori aperti a tutti e tutte (per scuole e gruppi è obbligatoria la prenotazione) e conferenze: tra gli ospiti Giuseppe Anerdi e Paolo Dario su “Compagni di viaggio, robot, androidi e altre intelligenze” (venerdì alle 9); Vincenzo Vespri su “Cos’è la matematica” (venerdì alle 10.30), Gian Francesco Giudice del Cern su “Prima del big Bang, com’è iniziato l’Universo e cos’è avvenuto prima” (sabato alle 9), Michela Matteoli della Humanitas Huniversity su “Il talento del cervello” (sabato alle 10.30), Enrico Pedemonte su “L’era della sfifucia, dal creazionismo all’intelligenza artificiale”, Filippo Bonaventura su “Storia di un protone” (sabato alle 17.30); Susanna Corti del CNR parlerà di “Clima 2050, la matematica e la fisica per il futuro del sistema Terra” (lunedì alle 9), Giorgio Chinnici terrà una conferenza dal titolo “Il segreto del nucleo, il mondo nel cuore della materia” (lunedì alle 10.30).
La scienza in sardo e l’Einstein Telescope
Tra le novità di quest’anno le conferenze in sardo con due fisici dell’Università di Cagliari: sabato 11 novembre alle 16.30 Matteo Tuveri parlerà di “S’universu a bolu” (Giulia Sanna lo intervista qui), di seguito Mariano Cadoni racconterà “Non esti sceti una mela chi nd’arruidi: istoria de sa forza de gravidadi”. Altro appuntamento da segnare in agenda la tavola rotonda dedicata all’Einstein Telescope (ne abbiamo parlato qui), in programma domenica 12 alle 10, e il corso di formazione per giornalisti “La falsa scienza, come intercettare le fake news“, con Carla Romagnino, Micaela Morelli, Giulia Manca, Luisella Seveso e Maria Del Zompo mercoledì 15 novembre alle 10 nell’aula magna del Liceo Pacinotti. Oltre all’Exmà, altri spazi cittadini saranno coinvolti con laboratori, mostre, visite: il Parco Naturale regionale Molentargius, i Giardini Pubblici, il Museo di Zoologia, il Museo di Fisica, la Biblioteca Emilio Lussu. Venerdì mattina, inoltre, si potrà visitare il Sardinia Radio Telescope di San Basilio con gli esperti dell’Istituto nazionale di astrofisica Silvia Casu e Paolo Soletta.
Gli altri appuntamenti
Il festival proseguirà poi a Nuoro, Oristano, Siniscola, Senorbì, Isili, Igleisas; tra gli incontri da segnalare quello con il fotografo naturalista Domenico Ruiu che martedì 14 novembre alle 9 nell’auditorium della Biblioteca Satta a Nuoro parlerà di animali di Sardegna; la conferenza di Telmo Pievani “Serendipità”, mercoledì 15 alle 9 a Oristano, Liceo Mariano IV; la presentazione di “Happy Planet, guida ai grandi temi dell’ambiente” di Luca Fiorani.
Tutti gli appuntamenti del FestivalScienza, realizzato con il patrocinio e il contributo di Commissione Nazionale Italia per l’UNESCO, assessorato regionale della Pubblica Istruzione della Sardegna, assessorato alla Cultura del Comune di Cagliari, Città Metropolitana di Cagliari, Università degli Studi di Cagliari, CNR Consiglio Nazionale delle Ricerche, Science On Stage Italia, Fondazione di Sardegna, sono gratuiti e aperti a tutti e tutte. Il programma completo si trova qui.